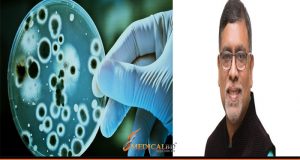

আকাশ নামে এক চিকিৎসক আত্মহত্যা করায় পুরুষ জাতির মাথায় আকাশ ভেঙে পড়ল। পুরুষ রক্ষা সমিতির ব্যানারে অনেকে বিচারের আগেই রায় ...
Read More »Tag Archives: healthtipsbd
“আজ বিশ্ব ক্যান্সার দিবস – আসুন ক্যান্সারকে না বলি”
আজ “বিশ্ব ক্যান্সার” দিবস। প্রতিবছরের ন্যায় আজকেও দিবসটি পৃথিবী ব্যাপী পালিত হচ্ছে। ক্যান্সার থেকে বাঁচতে একটু সচেতনতাই যথেষ্ট। সচেতনতাই পারে ...
Read More »মাথা ব্যথা দূর করার ৫টি যাদুকরী কৌশল
মাথা ব্যথা, উফ:: শুনলেই মাথা ব্যথা অনুভূত হতে শুরু করে। আসলেই মাথা ব্যথা এ এক বিশাল বিড়ম্বনা। মাথা ব্যথা যার ...
Read More »প্রিয়নবী হযরত মোহাম্মদ (সা:) এর এর কিছু অমূল্য উপদেশ
বিশ্ববাসীর জন্য রহমত হিসেবে বিশ্বনবী হযরত মুহাম্মদ সাল্লাল্লাহু আলাইহি ওয়াসাল্লামের আগমন হয়েছিল । আমাদের প্রিয় নবী হযরত মুহাম্মদ সাল্লাল্লাহু আলাইহি ...
Read More »নারীর মন বুঝতে ৬টি অন্যরকম উপায়
আমরা জানি নারী মন মানেই এক বিশাল জগত। নারী মন বোঝা কোন সহজ কাজ নয়, নারীর মন মানেই ভিন্ন জগত ...
Read More »হাসপাতালের হিসাবরক্ষক জুয়েল শতকোটি টাকার মালিক!!
ডেস্কঃ মহাখালী বক্ষব্যাধি হাসপাতালের তৃতীয় শ্রেণির কর্মচারী (হিসাবরক্ষক) লিয়াকত হোসেন জুয়েল মাত্র ১৫ বছরেই শতকোটি টাকার উর্দ্ধে সম্পদের। দুর্নীতি দমন কমিশন ...
Read More »চিকিৎসা বিজ্ঞানের গবেষণায় আরো বেশি জোর দিতে স্বাস্থ্যমন্ত্রী জাহিদ মালেকের নির্দেশ
স্বাস্থ্য ও পরিবার কল্যাণ মন্ত্রী জাহিদ মালেক দেশে চিকিৎসা বিজ্ঞানের গবেষণায় আরো নজর দিতে বঙ্গবন্ধু শেখ মুজিব মেডিকেল বিশ্ববিদ্যালয়সহ সব ...
Read More »উলঙ্গ হয়ে ঘুমানোর উপকারিতাগুলো জানলে অবাক হবেন!!
নিশ্চিয় অবাক হচ্ছেন এ কেমন কথা আবার। হয়তো ইতিপূর্বে কোনদিন শুনেননি তাই অবাক হচ্ছেন। আর হ্যাঁ অবাক হবারই কথা। কারণ ...
Read More »যেসকল রোগে ধনে বীজ খাওয়া নিষেধ
ধনে বীজ একটি রন্ধন সহযোগি রান্নার উপকরণ। আমরা প্রায় নিত্য দিনই তরকারি, সালাদ, স্যুপ ইত্যাদি প্রায় সব কিছুতেই ব্যবহার করে ...
Read More »মলদান বা “পুপু ডোনেশন” – বাঁচাতে পারে লক্ষ জীবন
আমরা সবাই কমবেশি রক্তদান বা ব্লাড ডোনেশনের সাথে পরিচিত। কিন্তু পুপ বা স্টুল ডোনেশন, সহজ বাংলায় যাকে বলা চলে মলদান; ...
Read More » medicalbd সাস্থের সকল খবর।
medicalbd সাস্থের সকল খবর।